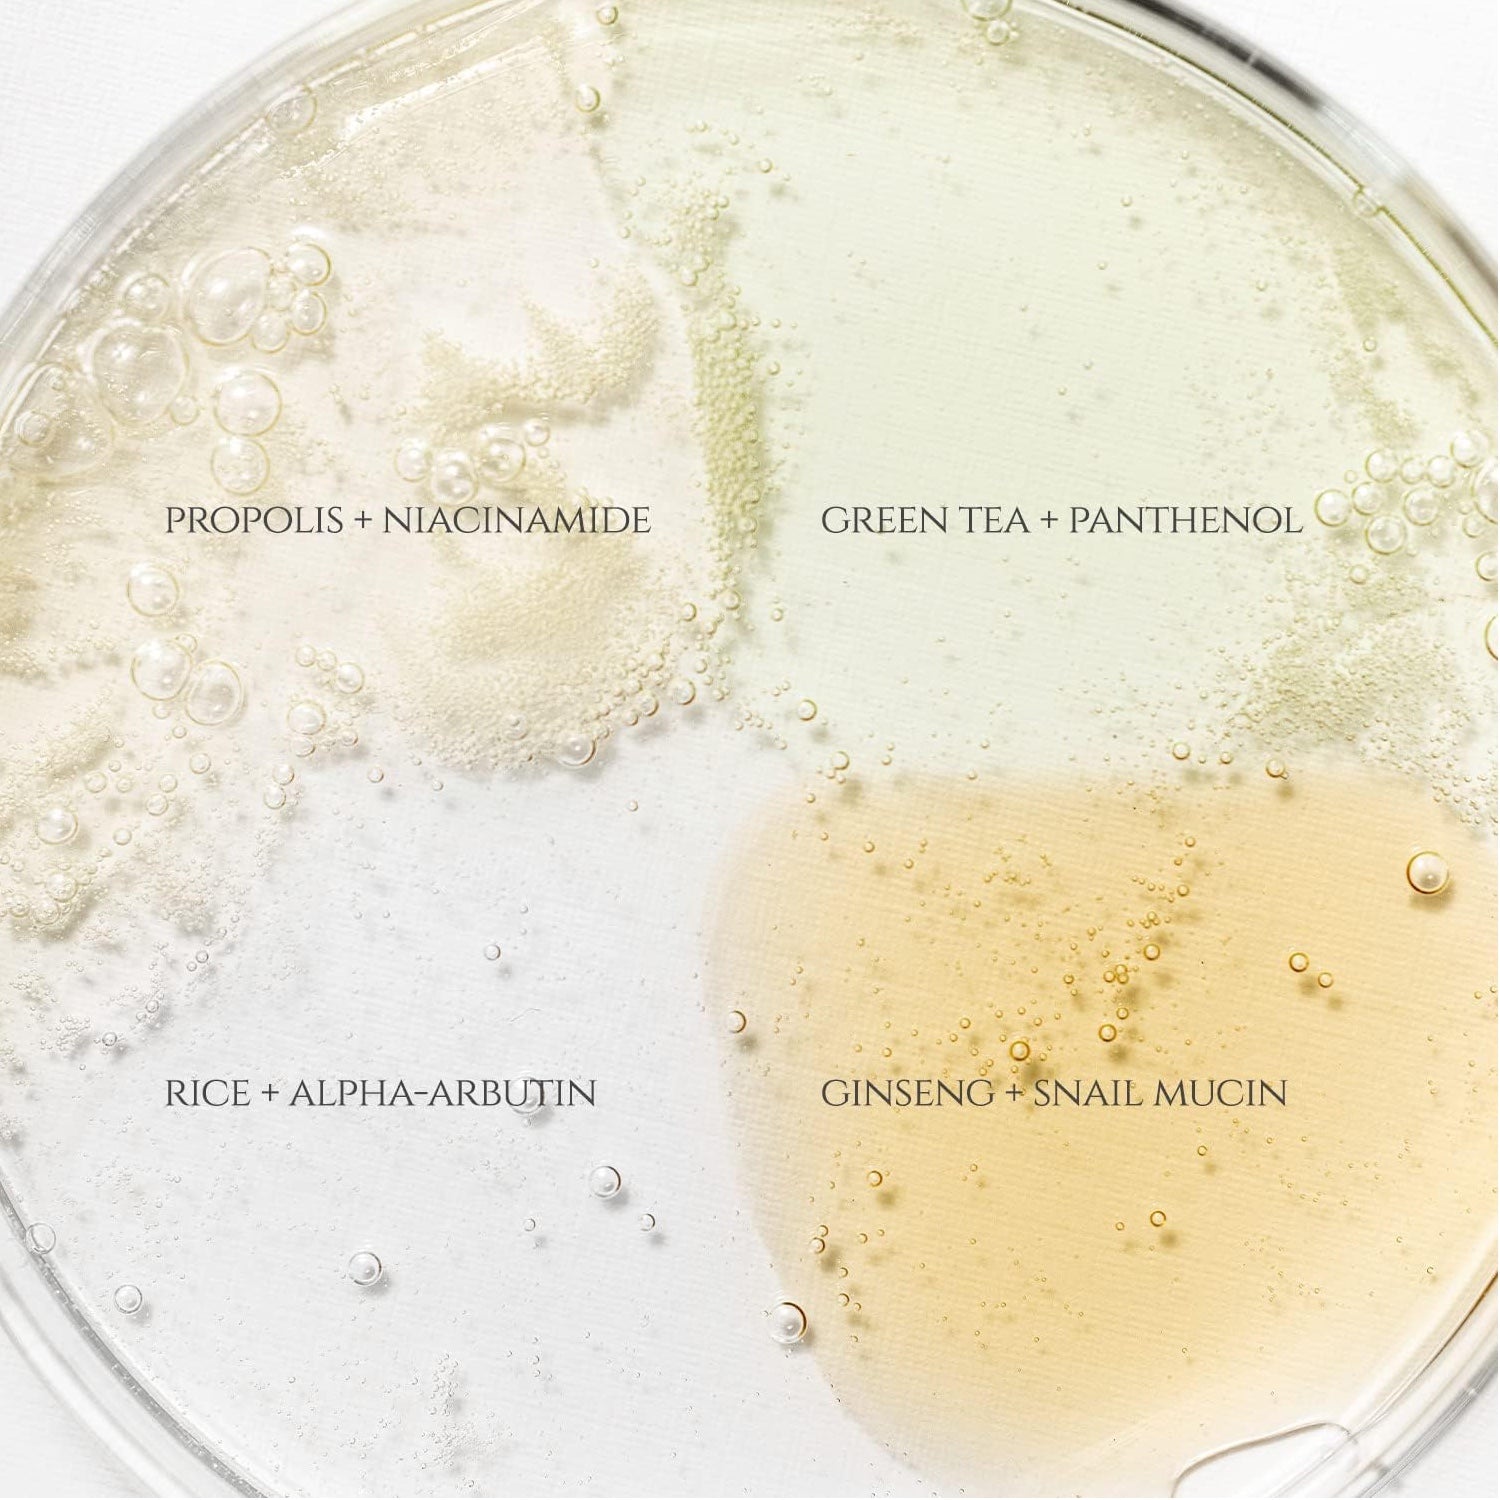

BEAUTY OF JOSEON HANBANG SERUM DISCOVERY KIT
THE 'HANBANG DISCOVERY KIT' WAS CREATED FOR THOSE WHO WANT TO FIND OUT WHICH OF THE FOUR BOJ SERUMS IS BEST FOR THEIR SKIN.
WHAT IT IS
This is a 10ml mini-size set with 4 types of serums so that you can choose to use or layer them according to your skin type or skin issues. Experience a wonderful journey to find the right product for you before taking the plunge on a full-size bottle.
Calming Serum: Green Tea + Panthenol 10ml
Solution: Green tea leaf water 76% + Panthenol 2%
Notable ingredients: Centella Asiatica Extract, Artemisia Vulgaris Extract, Sodium Hyaluronate
Texture: Watery and lightweight texture
Benefits: Soothing, Calming
Glow Serum : Propolis + Niacinamide 10ml
Solution : Propolis Extract 60% + Niacinamide 2%
Notable ingredients: Betaine Salicylate (BHA), Tamanu Oil, Tea Tree Extract
Texture: Honey-like texture
Benefits: Anti-acne, Anti-inflammation
Glow Deep Serum: Rice + Alpha-Arbutin 10ml
Solution: Rice bran water 68% + Alpha-Arbutin 2%
Notable ingredients: Glycerin, Niacinamide, Soybean Seed Extract, Barley Extract, Rice Extract, Sesame Extract
Texture: Watery and lightweight texture
Benefits: Anti-pigmentation, Brightening
Revive Serum : Ginseng + Snail Mucin 10ml
Solution: Ginseng Root Water 63% + Snail Mucin 3%
Notable ingredients: Ginseng Root Extract, Adenosine, Matsutake Extract
Texture: Lightweight, Mucin-like texture
Benefits: Anti-wrinkle, Anti-pigmentation
HOW TO USE
Apply 2-3 drops of serum onto the skin and pat gently to help absorption.
INGREDIENTS
CAUTION
For external use only.
Avoid contact with eyes.
Discontinue use if rash, redness, or itching occurs. Consult your physician if irritation persists.
We highly recommend to conduct a skin patch test on your arms before applying it directly to the face to avoid any allergic reactions.
Store in a cool and dry place.
Keep it out of the reach of children.
PLEASE NOTE
Ingredients are subject to change at manufacturer's discretion. For the most complete and up-to date list of ingredients, please refer to the product packaging.
Related Products
-
Cicapair Tiger Grass Color Correcting Treatment Spf 22 Pa++ 50ml$72.00
$106.00DR. JART+ CICAPAIR TIGER GRASS COLOR ...DR. JART+ CICAPAIR TIGER GRASS COLOR CORRECTING TREATMENT A GREEN-TO-BEIGE COLOUR-CORRECTING TREATMENT THAT CORRECTS REDNESS AND HELPS PROTECT SKIN FROM EN... -
Advanced Snail 96 Mucin Power Essence$29.00ADVANCED SNAIL 96 MUCIN POWER E...ADVANCED SNAIL 96 MUCIN POWER ESSENCE Enriched with 96.3% skin-boosting ingredient snail secretion filtrate Light-weight ...
-
Acne Pimple Master Patch - 24patches$6.00COSRX ACNE PIMPLE MASTER PATCH ...COSRX ACNE PIMPLE MASTER PATCH - 24PATCHES COSRX Acne Pimple Master Patch is a hydrocolloid patch that focuses on treating acne skin concerns.Aloe Vera Gel 300ml$9.90
$13.00NATURE ...NATURE REPUBLIC ALOE VERA GEL Soothing and moisture aloe vera 92% soothing gel. Enriched with natural aloe ...Relief Sun: Rice + Probiotics SPF50+ Broad Spectrum 50ml$31.00BEAUTY OF JOSEON ...BEAUTY OF JOSEON Relief Sun : Rice + Probiotics SPF50+ Fitted with broad-spectrum SPF 50+ PA++++ to fend off UVA and UVB r...SENKA Perfect Whip Facial Foam Cleanser 120g$13.90$19.90Shiseido Senka Perfect Whip Fac...Shiseido Senka Perfect Whip Facial Foam Cleanser Shiseido Senka Perfect Whip is a Japanese facial cleanser with a rich, whipped foam texture that effecti...Softymo Speedy Cleansing Oil 240ml$16.90$21.90KOSE SOFTYMO SPEEDY CLEANSING O...KOSE SOFTYMO SPEEDY CLEANSING OIL 240ML Cleansing oil removes makeup, including stubborn mascara, as well as dead skin cells and excess dirt, without leaving a...Full Eyelash Curler-213$29.90SHISEIDO FULL EYELASH CURLER-21...SHISEIDO FULL EYELASH CURLER-213 SHISEIDO Eyelash Curler 213 – Accentuate your eyes by curling your eyelashes. Curl the lash before applying mascara or false l...Senka Perfect Whip Collagen Facial Foam Cleanser 120g$13.90$19.90Shiseido Senka Perfect Whip Col...Shiseido Senka Perfect Whip Collagen Shiseido Senka Perfect Whip Collagen is a Japanese facial cleanser with a rich, whipped foam texture that effectivel...Hatomugi Skin Conditioning Toner 500ml$19.90NATURIE HATOMUGI SKIN CONDITION...NATURIE HATOMUGI SKIN CONDITIONING TONER 500ML This coix seed lotion toner is a cult-favorite in Japan. It deeply penetrates the skin t...Clear Fit Master Patch 10mm - 18patches$5.50$6.00COSRX FIT MASTER PATCH 10MM - 1...COSRX FIT MASTER PATCH 10MM - 18PATCHES Matt, Gradient, Ultra thin! Adheres to the skin naturally, perfect for daytime use since ...Melano CC Intensive Anti-Spot Essence 20ml$29.00ROHTO MELANO CC INTENSIVE ANTI-...ROHTO MELANO CC INTENSIVE ANTI-SPOT ESSENCE The most popular product from the Rohto Melano CC line. The Melano CC essence is formulated with active vitami...Unicharm - Silcot 1/2 Cotton Pads (40pcs)$6.90$8.90Unicharm - Silcot 1/2 Cotton Pads (40pcs)Unicharm - Silcot 1/2 Cotton Pads (40pcs) If you want lotion to penetrate the skin without waste.Makes skin amazingly moist with 50% less lotion. Amazingly moist with 50% les...Advanced Snail 92 All in one Cream 100ml$32.00COSRX ADVANCED SNAIL 92 ALL IN ...COSRX ADVANCED SNAIL 92 ALL IN ONE CREAM Glow-Up in One Step – Powered by Snail Mucin!That plump skin with full of nourishment ! <...Salicylic Acid Daily Gentle Cleanser 150ml$17.00COSRX SALICYLIC ACID DAILY GENT...COSRX SALICYLIC ACID DAILY GENTLE CLEANSER COSRX Salicylic Acid Daily Gentle Cleanser is a foam cleanser for oily skin, containing botanical purifying in...Hatomugi Skin Conditioning Gel Moisturizer 180g$26.90NATURIE HATOMUGI SKIN CONDITION...NATURIE HATOMUGI SKIN CONDITIONING GEL 180G A gentle, multi-purpose moisturizer for face and body. Features a lightweight, refr...Low pH Good Morning Gel Cleanser 150ml$17.00COSRX LOW PH GOOD MORNING GEL C...COSRX LOW PH GOOD MORNING GEL CLEANSER A super gentle cleanser that's great for your morning wash, this low pH formula gel cleanser doesn't strip your sk...Fino Premium Touch Hair Oil 70ml$26.90$29.00SHISEIDO FINO PREMIUM TOUCH HAI...SHISEIDO FINO PREMIUM TOUCH HAIR OIL Intensive repair for damaged hair, leaving the hair shiny and super smooth. Fino Premium Touch ...Shu Uemura Eyelash Curler$55.00$62.00SHU UEMURA EYELASH CURLER...SHU UEMURA EYELASH CURLER Shu Uemura Eyelash Curler for Natural All Day Curly Lashes, Best selling eyelash curler in Japan!! The award winni...Biore UV Aqua Rich Protect Mist SPF50 Broad Spectrum$17.99$24.90KAO BIORE UV AQUA RICH PROTECT MIST- THE WA...KAO BIORE UV AQUA RICH PROTECT MIST- THE WATER-BASED SUNSCREEN GOES ON LIKE WATER AND TRANSORMS INTO A WATER-RICH, MASK-LIKE TEXTURE THAT ADHERES AND CONFORMS PERFECTLY TO THE SKIN. Dis...DISPOSABLE FACE TOWEL 80sheets x 3packs$29.67$34.90ITO Tissue is made of 100% cotton non-woven ...ITO Tissue is made of 100% cotton non-woven fabric, soft like baby skin, highly absorbent, and not easy to become small pieces, significantly reducing energy and carbon emissions with its patent...Melano CC Vitamin C Premium Essence 20ml$39.00ROHTO MELANO CC VITAMIN C PREMI...ROHTO MELANO CC VITAMIN C PREMIUM ESSENCE A brightening vitamin C essence that absorbs deep into the skin surface with a unique formula.Fino Premium Touch Shampoo 550ml -Nourish & Recitalize$24.90$34.90SHISEIDO FINO PREMIUM TOUCH SHA...SHISEIDO FINO PREMIUM TOUCH SHAMPOO 550ML -NOURISH & RECITALIZE This rejuvenating shampoo is formulated to provide care to dry, damaged, permed and colored...Unicharm Silcot Velvety Touch VR Cotton 82 Puffs$3.45$6.90UNICHARM SILCOT VELVETY TOUCH C...UNICHARM SILCOT VELVETY TOUCH COTTON Super-soft cotton pads stay dense and puffy, thanks to the unique veil wrap around the cotton fibers that prevents th...Aha Bha Pha 30 Days Miracle Toner 150ml$39.00SOMEBYMI AHA. BHA. PHA 30 DAYS MIRACL...SOMEBYMI AHA. BHA. PHA 30 DAYS MIRACLE TONER This toner works wonder on your skin in just 30 days! Suitable for sensitive and acne-prone skin, the toner is...Radiance Cleansing Balm 100ml$32.00BEAUTY OF JOSEON RADIANCE CLEANSING B...BEAUTY OF JOSEON RADIANCE CLEANSING BALM This renewed version of Radiance Cleansing Balm presents an upgraded formula that thoroughly removes all traces of...Auto Eyebrow Pencil - 05 Dark Brown 0.3g$10.00INNISFREE AUTO EYEBROW PENCIL -...INNISFREE AUTO EYEBROW PENCIL - 05 DARK BROWN 0.3G Eyebrow pencil with an oval-shaped tip that allows for easy creation of your desired brow look. ...Dynasty Cream 50ml$41.00Beauty world natural eye tape 30Pairs$8.90LUCKY TRENDY BEAUTY WORLD NATUR...LUCKY TRENDY BEAUTY WORLD NATURAL EYE TAPE 30PAIRS Create subtle, natural-looking double eyelids with ease. This gentle, transparent tap...M Perfect Cover BB Cream Spf42 -#23 Natural Beige 50ml$25.00MISSHA - M PERFEC...MISSHA - M PERFECT COVER BB CREAM SPF42 PA+++ - #23 NATURAL BEIGE Multi-functional BB cream conceals, protects, whitens and smoothens out lines and w...Oil-Free Ultra-Moisturizing Lotion with Birch Sap 100ml$32.00COSRX OIL-FREE ULTRA-MOISTURIZI...COSRX OIL-FREE ULTRA-MOISTURIZIN LOTION WITH BIRCH SAP Daily moisturizer for all skin type and all situation! The weightles...AHA/BHA/PHA 30 Days Miracle Cream 60g$42.00SOME BY MI AHA/BHA/PHA 30 DAYS ...SOME BY MI AHA/BHA/PHA 30 DAYS MIRACLE CREAM A multi-purpose moisturizer with 4-Cica Care that shields troubled skin from irritation.1025 Dokdo Toner 200ml$22.00ROUND LAB 1025 DOKDO TONER 200ML A moisture boosting toner that removes old dead sk...
Heroine Make Micro Mascara Advanced Film #01 Jet Black 4.5g$29.90KISSME HEROINE MAKE MICRO MASCA...KISSME HEROINE MAKE MICRO MASCARA ADVANCED FILM -#01 JET BLACK Experience Flawless And Well Defined Lashes Like Never Before With Our Newly Upgraded Formu...Clean It Zero Original Cleansing Balm 100ml$37.00BANILA CO. CLEAN IT ZERO ORIGIN...BANILA CO. CLEAN IT ZERO ORIGINAL CLEANSING BALM 100ML Our bestselling Clean It Zero Original Cleansing Balm offers a soft, warm touch to your skincare routine...Laurier Ultra Block Until Morning Secure Panty Pads Super Absorbent M-L Size 48cm 5 Pieces$14.90$15.90KAO LAURIER ULTRA BLOCK UNTIL M...KAO LAURIER ULTRA BLOCK UNTIL MORNING SECURE PANTY PADS SUPER ABSORBENT M-L SIZE 48CM 5 PIECES Are you ready for nights free from worries? Introducing the Kao ...Hyaluronic Acid Intensive Cream 100ml$33.00COSRX HYALURONIC ACID INTENSIVE CREAM...COSRX HYALURONIC ACID INTENSIVE CREAM Superbly hydrating cream contains 3,000ppm of sodium hyaluronate to deeply moisturize skin and help strengthen its moisture bar...Okamoto 0.01 Zero One #L size$17.90$22.90SENKA Perfect White Clay Face Wash Foam 120g$13.90$19.90SHISEIDO SENKA Perfect White Cl...SHISEIDO SENKA Perfect White Clay Face Wash Foam 120g Shiseido Senka Perfect Whip White Clay contains white clay and W hyaluronic acid that efficiently a...All Clean Balm 120ml$30.00HEIMISH ALL CLEAN BALM 120MLHEIMISH ALL CLEAN BALM 120ML Heimish All Clean Balm is a multi cleansing balm which contains natural aroma oil for easier, faster and perfect cleansing on make...No-Sebum Mineral Pact 8.5g$26.00INNISFREE NO SEBUM MINERAL PACTINNISFREE NO SEBUM MINERAL PACT Achieve the most refreshing no-makeup makeup look with Innisfree No Sebum Mineral Pact.Revive Serum: Ginseng + Snail Mucin 30ml$29.00BEAUTY OF JOSEON ...BEAUTY OF JOSEON REVIVE SERUM: GINSENG + SNAIL MUCIN Enriched with 63% ginseng root wate...Pig Nose Clear Blackhead 3 Step Kit 1 Sheet$6.00HOLIKA HOLIKA PIG NOSE CLEAR BL...HOLIKA HOLIKA PIG NOSE CLEAR BLACKHEAD 3 STEP KIT Say goodbye to your blackheads with Pig Nose Clear Series. The HOLIKA HOLIKA Pig Nose ...HYALURONIC ACID HYDRA POWER ESSENCE$32.00Dewy skin from deep skin layers! Contains high purity of natural hydrating Sod...All Around Safe Block Aqua Sun Gel SPF50+ Broad Spectrum$22.00ALL AROUND SAFE BLOCK AQUA SUN ...ALL AROUND SAFE BLOCK AQUA SUN GEL SPF 50+ BROAD SPECTRUM WATER AND SWEAT RESISTANT A hydrating sunscreen infuse...Birch Juice Moisturising Sunscreen Spf50+ Broad Spectrum 50ml$35.00ROUND LAB BIRCH JUICE MOISTURISING SUNSCREE...ROUND LAB BIRCH JUICE MOISTURISING SUNSCREEN SPF50+ BROAD SPECTRUM THE NATURAL BIRCH SAP AND VITA HYALURONIC ACID, WHICH GREW UP WITH THE FRESH ENERGY OF THE COOL WIND, MOIS...Fino Premium Touch Conditioner 550ml -Repair & Restore$24.90$34.90SHISEIDO FINO PREMIUM TOUCH CON...SHISEIDO FINO PREMIUM TOUCH CONDITIONER 550ML -REPAIR & RESTORE A moisture-rich conditioner for dry and damaged hair. It penetrates ...Senka Perfect Whip Acne Care Face Wash Cleansing Foam 120g$13.90$19.90Senka Perfect Whip Acne Care Fa...Senka Perfect Whip Acne Care Face Wash Cleansing Foam Shiseido Senka Perfect Whip Herb Face Wash Cleanser creates an exceptionally rich foam to bring use...AHA/BHA Clarifying Treatment Toner 150ml$22.00COSRX AHA/BHA CLARIFYING TREATM...COSRX AHA/BHA CLARIFYING TREATMENT TONER A mild daily toner for clear, supple skin. Formulated with AHA, BHA and purifying botanica...Recently Viewed Products
![The Cosmetic Store Auckland]()
OUR STORE
City Centre:
Level 1, 10 Victoria Street East, Auckland 1010
Mon~Sun: 11am - 7pm
![100% NZ Own and Operated]() Proudly 100% New Zealand owned and operated
Copyright © 2022, The Cosmetic Store New Zealand
Proudly 100% New Zealand owned and operated
Copyright © 2022, The Cosmetic Store New Zealand![Visa]()
![Master Cars]()
![AfterPay]() LoadingLoading
LoadingLoading